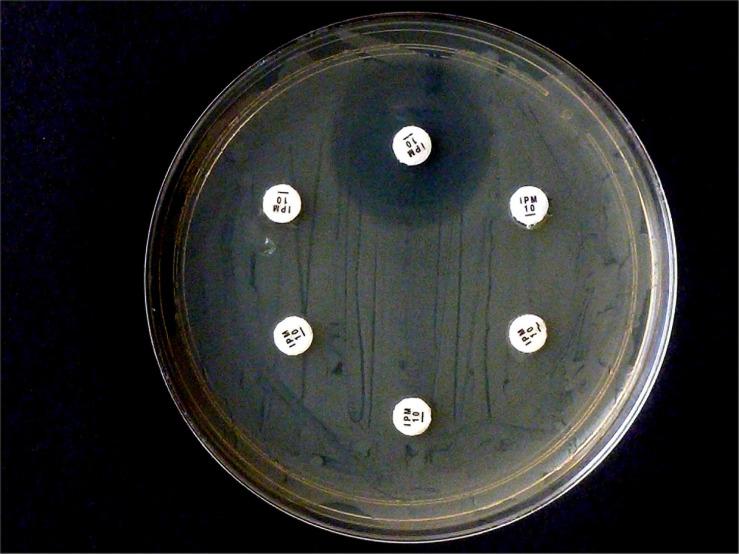
https://cdn.ncbi.nlm.nih.gov/pmc/blobs/c049/7719632/981341dd68d9/fmicb-11-588887-g002.jpg
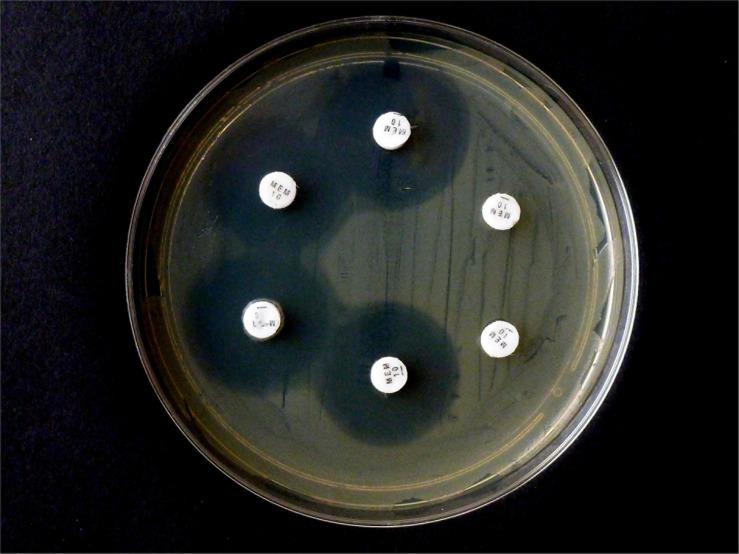
https://cdn.ncbi.nlm.nih.gov/pmc/blobs/c049/7719632/210d47b4889b/fmicb-11-588887-g003.jpg

用于检测碳青霉烯酶和碳青霉烯失活AmpCβ-内酰胺酶的新型CarbaLux检测法
The Novel CarbaLux Test for Carbapenemases and Carbapenem Deactivating AmpC Beta-Lactamases.
作者信息
Pfaendler Hans Rudolf, Schmidt Hans-Ulrich, Freidank Heike
机构信息
Department of Chemistry, Ludwig-Maximilians University, Munich, Germany.
Department of Medical Microbiology, München Klinik gGmbH, Munich, Germany.
出版信息
Front Microbiol. 2020 Nov 23;11:588887. doi: 10.3389/fmicb.2020.588887. eCollection 2020.
OBJECTIVES
To evaluate the rapid phenotypic CarbaLux test for routine diagnostics in the medical laboratory in a proof of concept study.
METHODS
isolates of Gram-negative bacteria suspicious for carbapenem resistance including (67), (10), (5), and (1) species, collected between 2016 and 2018 from in-patients, were tested for carbapenemase activity using a novel fluorescent carbapenem. When subjected to extracted bacterial carbapenemases its fluorescence disappears. All bacteria to be tested were cultured on Columbia blood agar and few on other commercial media. MALDI TOF MS, molecular assays, automated MIC testing, and in part, agar diffusion tests served to characterize the isolates. For comparison, few selected bacteria were also investigated by prior phenotypic tests for carbapenemase detection.
RESULTS
Under UV light, the CarbaLux test allowed a rapid detection of 39/39 carbapenemase-producing bacteria, including 15 isolates with OXA carbapenemases (e.g., OXA-23, OXA-24/40-like OXA-48-like or OXA-181). Several isolates had low MICs but still expressed carbapenemases. Among spp., it detected six strains with hyper-produced AmpC beta-lactamases, which deactivated carbapenems but were not detectable by prior rapid phenotypic assays. An unexpected high carbapenemase activity appeared with these enzymes. They were identified as AmpC variants by inhibition with cloxacillin.
CONCLUSION
Other than prior rapid phenotypic assessments for carbapenemases, which use secondary effects such as a change of pH, the inactivation of the fluorescent carbapenem substrate can be visualized directly under UV light. The new test works at 100 to 200-fold lower, therapy-like substrate concentrations. It takes advantage of the high substrate affinity to carbapenemases allowing also the detection of less reactive resistance enzymes via a trapping mechanism, even from bacteria, which might appear unsuspicious from initial antibiograms. The novel fluorescence method allows simple and safe handling, reliable readings, and documentation and is suitable for primary testing in the clinical laboratory.
目的
在一项概念验证研究中评估用于医学实验室常规诊断的快速表型CarbaLux试验。
方法
2016年至2018年期间从住院患者中收集的疑似对碳青霉烯类耐药的革兰氏阴性菌分离株,包括(67种)、(10种)、(5种)和(1种),使用一种新型荧光碳青霉烯类药物检测其碳青霉烯酶活性。当暴露于提取的细菌碳青霉烯酶时,其荧光消失。所有待检测细菌均在哥伦比亚血琼脂上培养,少数在其他商业培养基上培养。基质辅助激光解吸电离飞行时间质谱(MALDI TOF MS)、分子检测、自动化最低抑菌浓度(MIC)检测以及部分琼脂扩散试验用于鉴定分离株。为作比较,少数选定细菌还通过先前用于检测碳青霉烯酶的表型试验进行了研究。
结果
在紫外光下,CarbaLux试验能够快速检测出39/39株产碳青霉烯酶细菌,包括15株携带OXA碳青霉烯酶的分离株(如OXA-23、OXA-24/40样、OXA-48样或OXA-181)。一些分离株的MIC值较低,但仍表达碳青霉烯酶。在属中,它检测出6株超产AmpCβ-内酰胺酶的菌株,这些酶可使碳青霉烯类失活,但先前的快速表型检测无法检测到。这些酶表现出意外的高碳青霉烯酶活性。通过氯唑西林抑制作用将它们鉴定为AmpC变体。
结论
与先前用于检测碳青霉烯酶的快速表型评估不同,后者利用诸如pH值变化等次要效应,而荧光碳青霉烯类底物的失活可直接在紫外光下观察到。新试验在低100至200倍的类似治疗底物浓度下即可起作用。它利用了底物对碳青霉烯酶的高亲和力,甚至通过捕获机制也能检测到反应性较低的耐药酶,即使是从最初的抗菌谱来看可能不可疑的细菌中也能检测到。这种新型荧光方法操作简单、安全,读数和记录可靠,适用于临床实验室的初步检测。